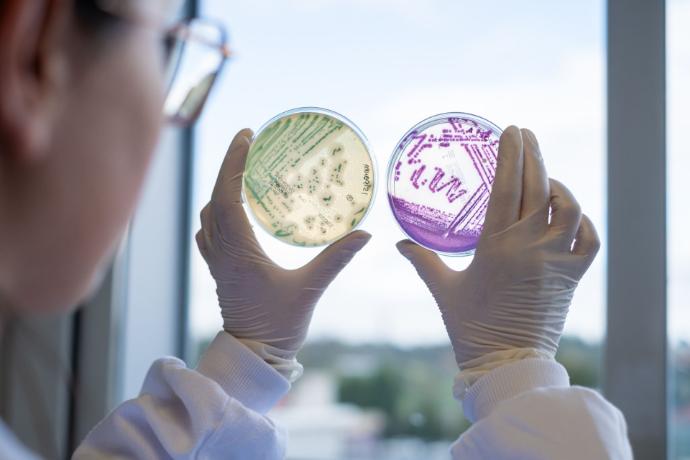

¿Qué son los Challenge Test?

Los challenge tests permiten comprobar cómo se comportan los microorganismos en los alimentos en condiciones controladas.
Son una herramienta esencial para garantizar la seguridad y estabilidad de nuevos productos y responder a la necesidad de las empresas de contar con datos fiables sobre la vida útil y la calidad microbiológica.
El laboratorio de ASINCAR cuenta con varios años de experiencia en la realización de estos ensayos, con el objetivo de reforzar la seguridad alimentaria, especialmente en alimentos listos para el consumo frente a la amenaza de Listeria monocytogenes.
¿Cómo pueden ayudarte?
Validación de la seguridad alimentaria y reducción de riesgos
Garantizamos la seguridad alimentaria,
especialmente para los alimentos listo para el consumo
Optimización de la vida útil y reformulación de productos
Determinamos el momento exacto en el cual el productos
dejan de ser microbiológicamente seguros
Ajuste y validación de procesos productivos
Conocer el proceso productivo,
se traduce en mejora de la seguridad alimentaria
¿Cuál es nuestra garantía?

Un Sello de Excelencia Único en España:
Acreditación ISO 20976-1 por ENAC
El laboratorio de ASINCAR está certificado por la Entidad Nacional de Acreditación (ENAC) para ensayos de desafío de Listeria monocytogenes para el estudio del potencial de crecimiento en productos cárnicos y productos lácteos en proceso de elaboración. Lo que convierte a nuestro laboratorio en un actor único en el panorama español yes que es el único laboratorio en toda España acreditado bajo la norma ISO 20976-1 para este tipo específico de ensayos de desafío.
Estudio del potencial de crecimiento y cinética de crecimiento
Esto garantiza que nuestros resultados son fiables, precisos y reconocidos a nivel internacional, proporcionando la evidencia científica necesaria para la seguridad y el cumplimiento de productos cárnicos y lácteos basados en EURL Lm TECHNICAL GUIDANCE DOCUMENT for conducting shelf-life studies on Listeria monocytogenes in ready-to-eat foods.